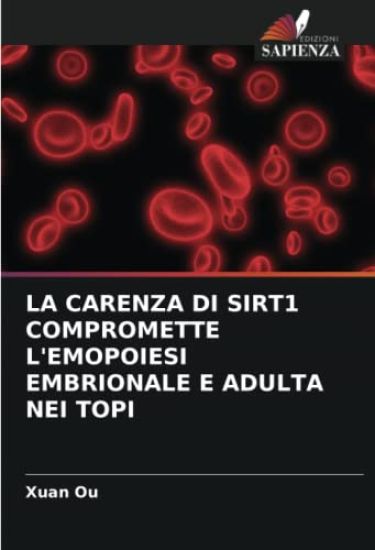
LA CARENZA DI SIRT1 COMPROMETTE L'EMOPOIESI EMBRIONALE E ADULTA NEI TOPI

S prikhodom nochi bolota oglashajutsja voem upyrej, i beda tomu, kogo temnota zastanet v puti. God nazad bolotnye tvari utaschili mladshego brata Mavny, Rasko, i vsja ee zhizn peremenilas: mat slegla ot bolezni, starshij brat stal neljudimym i vspylchivym, a sama Mavna budto oledenela, razuchilas radovatsja. Odnazhdy v derevne objavljaetsja neznakomets i darit Mavne ljagushachju shkurku, a vmeste s nej - nadezhdu, chto Rasko esche mozhno spasti. Mavne pridetsja shagnut za ogradu, v stylyj tuman, i lish Pokroviteli znajut, kto vstretitsja ej na etom puti. Upyri teper okhotjatsja ne tolko po nocham, i put stanovitsja vse opasnee. Mavna, Varde i Smorodnik uchatsja byt zaodno, chtoby dobitsja kazhdyj svoikh tselej i vyjasnit, dejstvitelno li brat Mavny obraschen v kozla. Ilar i Kupava skitajutsja po Udelam, spasajas ot vragov. Vokrug narastaet protivostojanie mezhdu charodejami, upyrjami i ljudmi, no pravdy net ni na odnoj storone. Skoro vspykhnet charodejskij ogon, i stanet jasno, kogo poglotit plamja, a kogo - tumannaja top. Zakonchennaja dilogija Anastasii Andrianovoj "Sonnye topi" v odnom komplekte: "Skvoz top i tuman" i "Cherez plamja i noch". Anastasija Andrianova - avtor populjarnykh dilogij "Sonnye topi" i "Mir Knjazhestv". Fentezi na osnove slavjanskikh skazok. Originalnaja interpretatsija upyrej i avtorskij mir! Teplye i ujutnye stseny kontrastirujut s mrachnymi i zhutkimi. Dilogija "Sonnye topi" napomnit, chto dazhe malenkaja iskorka nadezhdy sposobna stat pozharom-stremleniem.